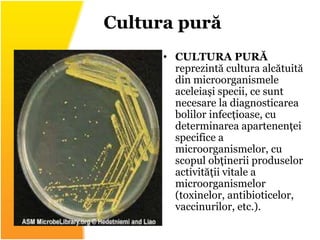
• CULTURA PURĂ
reprezintă cultura alcătuită
din microorganismele
aceleiași specii, ce sunt
necesare la diagnosticarea
bolilor infecțioase, cu
determinarea apartenenței
specifice a
microorganismelor, cu
scopul obținerii produselor
activității vitale a
microorganismelor
(toxinelor, antibioticelor,
vaccinurilor, etc.).
Cultura pură
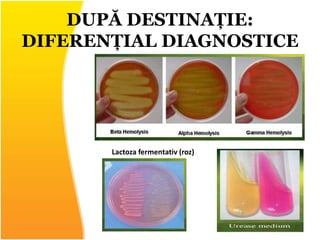
DUPĂ DESTINAȚIE:
DIFERENȚIAL DIAGNOSTICE
Lactoza fermentativ (roz)
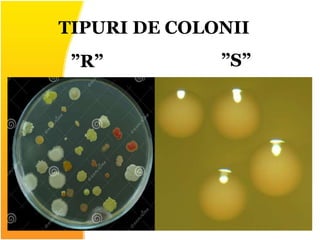
TIPURI DE COLONII
”R” ”S”

Metoda bacteriologică de diagnostic implică izolarea culturilor pure de microorganisme pentru identificarea bolilor infecțioase și obținerea produselor rezultate din activitatea lor. Mediile de cultură, necesare pentru creșterea bacteriilor, trebuie să ofere condiții optime pentru dezvoltare, să fie sterile și să nu conțină substanțe inhibitorii. Algoritmul investigației microbiologice și metodele de însămânțare sunt esențiale pentru analiza și caracterizarea coloniilor bacteriene.